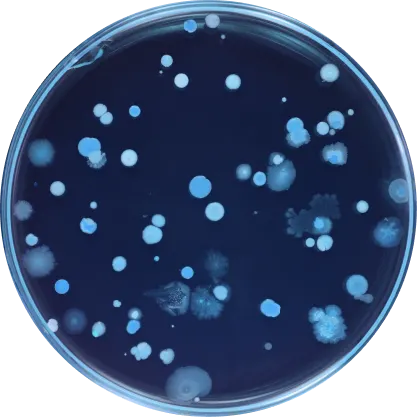

Engineered tosurvive.
Use the flexible grid system to create any layout. Each block can be placed in any of the columns.


Daily SynbioticDS-01
The probiotic that deliversresults in just 7 days
- ONGOINGRestore Gut Bacteria
- 7 DAYS Better Gut Health
- 4 WEEKS Smoother, Clearer Skin
- 3 MONTHS lmmune + Heart Health

VIACAP TECHNOLOGY
Many probiotics don'tmake it to the gut alive.Daily Synbiotic does.
- DS-01 delivers 50x more live bacteriathan the industry standard.
- PrebioticOuter CapsuleNon-fermentingprebiotic releases inthe upper Gl tract.
- Probiotic Inner Capsule Delivers live bacteriato the colon where it'sneeded most.

How to Use
- Days 1–3: Take 1 capsule daily on an empty stomach.
- Day 4 onward: Increase to 2 capsules daily.
- Best taken in the morning, before eating.
- No refrigeration required.
💡 Tip: If you experience mild digestive discomfort at the start, that’s normal—it means your gut is adjusting.
Benefits beyondyour gut.
Formulated with strains that support:Digestive Health Gut Barrier Integrity Gut Immune Function Cardiovascular Health Dermatological Health Micronutrient Synthesis
53.6 Billion AFUNo refrigeration required.
Explore our clinically studied strains.


Digestive Health / Gut lmmunity / Gut Barrier Integrity Probiotic Blend37.0 Billion AFU

Digestive Health / Gut lmmunity / Gut Barrier Integrity Probiotic Blend37.0 Billion AFU
Bifidobacterium longumSD-BB536-JP
Bifidobacterium breve SD-BR3-IT
Lactiplantibacillus plantarum SD-LP1-IT
Lacticaseibacillus rhamnosus SD-LR6-IT
Lacticaseibacillus rhamnosus HRVD113-US
Bifidobacterium infantis SD-M63-JP
Bifidobacterium lactis SD-BS5-IT
Bifidobacterium lactis HRVD524-US
Lactobacillus crispatus SD-LCR01-IT
Lacticaseibacillus casei HRVD300-US
Bifidobacterium breve HRVD521-US
Bifidobacterium longum HRVD90b-US
Bifidobacterium lactis SD150-BE
Limosilactobacillus fermentum SD-LF8-IT
Lacticaseibacillus rhamnosus SD-GG-BE
Limosilactobacillus reuteri RD830-FR

Dermatological Health Probiotic Blend3.30 Billion AFU

Dermatological Health Probiotic Blend3.30 Billion AFU
Ligilactobacillus salivarius SD-LS1-IT
Bifidobacterium lactis SD-CECT8145-SP
Bifidobacterium longum SD-CECT7347-SP
Lacticaseibacillus casei SD-CECT9104-SP

Cardiovascular Health Probiotic Blend5.25 Billion AFU

Cardiovascular Health Probiotic Blend5.25 Billion AFU
Lactiplantibacillus plantarum SD-LPLDL-UK
Bifidobacterium lactis SD-MB2409-IT

Micronutrient Synthesis Probiotic Blend8.05 Billion AFU

Micronutrient Synthesis Probiotic Blend8.05 Billion AFU
Bifidobacterium adolescentis SD-BA5-IT
Limosilactobacillus reuteri SD-LRE2-IT

Microbiota-Accessible Polyphenolic Precursors™ [MAPP]400mg

Microbiota-Accessible Polyphenolic Precursors™ [MAPP]400mg
Indian Pomegranate [whole fruit] (Punica granatum) (>40% Polyphenolic + Phenolic Bioactives)

Other Ingredients

Other Ingredients
Acid-Resistant Vegan Outer [hypromellose, chlorophyllin] and Inner [hypromellose, water] Capsules
Organic rice fiber
Organic rice extract blend
A new standardin probiotics.
Questions? We're here to help.

How do l take DS-01@ Daily Synbiotic?
How do l take DS-01@ Daily Synbiotic?
Adults—take 2 capsules daily, all at once. Preferably on an empty stomach to limit exposure to digestive enzymes and bile salts. However, you know your body best—if it’s more comfortable for you to take with food, please feel free to do so.
Why should l take DS-01 Daily Synbiotic?
Why should l take DS-01 Daily Synbiotic?
You are home to a community of trillions of microorganisms, including 38,000,000,000,000 bacteria that live in and on you. They perform critical functions like digesting food, managing inflammation, and synthesizing key vitamins, metabolites and neurotransmitters. This is the microbiome.
DS-01® is a probiotic and prebiotic formulated to provide benefits for gut immune function and whole-body health for adults ages 18+.
What does DS-01® Daily Synbiotic do?
What does DS-01® Daily Synbiotic do?
DS-01® contains probiotic strains that have been clinically and scientifically studied to provide benefits around gastrointestinal function, skin health, heart health, gut immune function, gut barrier integrity, and micronutrient synthesis. You may access the strain-specific clinical studies associated with each benefit in ourReference Library.
When will l feel something?
When will l feel something?
Everyone’s body is different, and the benefits you may ‘feel’ (ease of bloating, more regular bowel movements) are often just the most visceral ones.
It is normal to feel effects in the digestive tract in as little as 24-48 hours. Other longer term benefits like cardiovascular health and gut immune function may take longer, or you may not notice anything at all. That’s completely normal. As long as you continue your daily intake, those beneficial microbes are doing their work inside to program, sustain, and enhance your health.
Who should take DS-01e Daily Synbiotic?
Who should take DS-01e Daily Synbiotic?
DS-01® is meant for humans ages 18+.
Is DS-01@ Daily Synbiotic compatible with my diet or dietary restrictions?
Is DS-01@ Daily Synbiotic compatible with my diet or dietary restrictions?
DS-01® is tested for: Dairy, Gluten, Soy, GMOs, Nuts, Shellfish, Sesame, Glyphosate/AMPA, and 14 classes of allergens defined by European Food and Safety Authority (EFSA)
It adheres to the following diets: Vegan • Vegetarian • Ketogenic • Gluten-Free • Intermittent Fasting
Can l take this with other supplements? What about medications?
Can l take this with other supplements? What about medications?
DS-01® is safe to take with other supplements.
There are no known contraindications with DS-01® and any over the counter or prescription medications, though we encourage you to double check with your physician before adding our product to your regimen.
Is DS-01@ Daily $ynbiotic safe to take while l'm pregnant or breastfeeding?
Is DS-01@ Daily $ynbiotic safe to take while l'm pregnant or breastfeeding?
As with any dietary supplement or new health protocol contemplated during pregnancy or lactation, we recommend speaking with your physician or obstetrician before you start consuming DS-01® Daily Synbiotic.
Probiotics, in general, do not appear to pose any safety concerns for pregnant and lactating individuals. The current literature does not indicate an increase in adverse pregnancy outcomes when probiotics are used by healthy individuals.
Do lneed to refrigerate my D$-01® Daily Synbiotic?
Do lneed to refrigerate my D$-01® Daily Synbiotic?
The short answer is no. No refrigeration necessary.
It’s a question we receive often, since many probiotics are sold in the refrigerated section at grocery stores and retailers. However, contrary to perishable food products, refrigeration doesn’t mean "freshness" or superiority. In fact, if a probiotic does not survive at ambient temperature outside of the refrigerator, it can reflect weak stability of the product, low viable organism count, or inadequate overages in formulation.
If your home is consistently warmer than 79° F for extended periods, consider refrigerating in an oxygen tight container to avoid exposure to moisture.
What does mysubscription to DS-01® Daily Synbiotic include?
What does mysubscription to DS-01® Daily Synbiotic include?
Your monthly subscription includes a 30-day supply of DS-01®. Your first month’s shipment is your Welcome Kit. It includes a reusable glass jar holding your first month’s supply, some Seed reading materials, and a complimentary travel vial that holds a week’s worth of your DS-01®, so you never miss a day on the go.
Dol have to sign up for a subscription?
Dol have to sign up for a subscription?
Yes. We believe that probiotics and prebiotics, alongside diet, nutrition, exercise, and lifestyle, are cornerstone tools to building foundational health. Clinical research shows that continuous, daily intake is the best way to get the most out of your synbiotic. By signing up for a subscription, you’ll easily be able to build DS-01® into your routine.
But we want you to feel good about what you’re taking. That’s why we want you to try DS-01®, risk-free for 30 days. You may also reschedule or cancel your subscription easily from your account at any time.
What is your 30 day risk-free guarantee? Do you accept returns?
What is your 30 day risk-free guarantee? Do you accept returns?
If for any reason you are not satisfied with your purchase, you may request a refund within 30 days of delivery of your first order. We’ll refund you for the full cost of the product less shipping, VAT, and duties—no questions asked. Refunds apply to your first order only, not any subsequent shipments. For all subsequent shipments, you may reschedule or cancel at any time inyour Account.
Do you ship internationally?
Do you ship internationally?
Yes—find out more atseed.com/entire-world.
Is climate change real?
Is climate change real?
Yes.